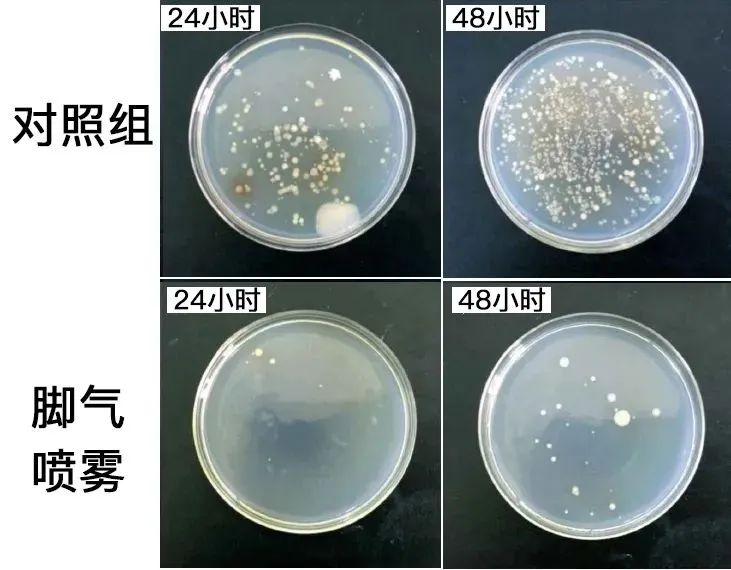

小来最近一看天气预报真是震惊了!才三月气温南方气温都到30度了,就连北方也有二十四五度。
本来天暖和了是好事,正好也快清明假期可以出去玩,但对于很多朋友来说,天热也带来了一个麻烦——脚气!

说脚气难受吧,它也不是什么大病,不值得为它去医院;但说脚气不难受吧,那肯定是骗人,特别是天热之后简直堪比上刑!
蒸桑拿般的唔了一天,脱鞋瞬间那浓烈冲鼻的味道....不仅会被大家嫌弃,还会被贴上“邋遢、不爱干净“的标签,遭受议论....

不仅如此,痒起来仿佛有千万只蚂蚁在脚上,越挠越痒,越痒越挠,一晚上要被痒醒2-3回,白天根本没有精力工作

脚部是人体汗腺约有25万条汗腺不断分泌汗液,平均每日穿鞋时长却超过12小时,在汗液和足底角蛋白的环境下,鞋袜容易滋生多种致病镇菌!

这些镇菌在封闭的鞋袜内,仿佛一个巨大的生化实验室,大肆繁育,引起e臭、瘙痒、溃烂、蜕皮

🦶气还容易传染!比如刚脱下的臭袜子,用过的脚盆沾满了脚气皮屑,一不小心就跑到家人身上。
孩子抵抗力弱,一旦染上,比大人难受10倍!

女性还要定期去检查妇科,因为脚气传染性强,不一定传染到脚,你懂得…

小编也有脚臭脚痒问题,每年都要犯2~3次,市面上买的药膏内含ji素,容易造成ji素依赖

小编曾以为要顶着🦶气过一生了,直到找到了这款【李时珍净笙集柏参足适爽保健喷剂】

它是河南中医💊大学博导团队研发而成,一上市就从69个对手中脱颖而出,有上百家权维机构认证!

博导研发团队基于李时珍《草本纲目》的精髓,以草本植物配方为主研制出这款足适爽喷剂

*自有版权,未经授权,盗图必究
选用天燃苦参、侧柏叶、蓖麻油、野菊花、白鲜皮、土茯苓6大草🌿成分,无ji素不依赖

*自有版权,未经授权,盗图必究
各种难以zhi愈、反复发zuo的🦶气、脚鲜甚至混合型脚部疑难杂症,都在它的陪伴下逐步好转

用过的粉丝家人也都是满满的好评,更有很多家人后台留言要再买一些!

*以实际使用效果为主,效果因人而异
小编自己1瓶还没用完,常年穿高跟鞋干裂的脚跟、脱皮的脚跟都变细嫩了~

*以实际使用效果为主,效果因人而异
市面上同款高品质的足适爽都要💰200+

咱们这款李时珍净笙集柏参足适爽扫码官方零售价也是159元/瓶!

*自有版权,未经授权,盗图必究
而今天我们跟品牌方争取到粉丝福利价39.9元/瓶
买2送1,79.8到手3瓶,单瓶低至26.6
买3送2,119.7到手5瓶,单瓶低至23.94

建议买3瓶装到手5瓶,趁优惠多买几瓶,给自己、伴侣、父母和孩子,一人健康,全家安心!
点击图片,立即购买▼

01
523次调试,只为双脚
打造中🌿脚臭、脚痒的蕞终克星
这支足适爽来自于李时珍中医研究所与河南中yi院联合研发,他们秉承“传承药圣李时珍,深耕中医养身”的理念

结合《本草纲目》的中医精粹,研发团队用心研制适合国人体质安全、有xiao的养护喷剂

*自有版权,未经授权,盗图必究
《本草纲目》这样记载苦参:去shi热、缓sao痒、止kui疡、除xiao臭味,是名副其实的“🦶气克星”!

基于苦参的强大功效和千年中医理论,辅以“止痒黄金”野菊花+“修富明星”白鲜皮+“jie毒皇后”侧柏3大名贵🀄️药材

*自有版权,未经授权,盗图必究
中🌿研发团队经300天、523次调试,为🦶气人群研制了这款足适爽去🦶气喷雾

实验数据表明:48小时后,对照组已被西菌占领,喷了去🦶气喷雾的培养皿,只有零星几个西菌,效果确实杠杠的!
质检过关!更验证确认这款足适爽喷剂没有添加有害成分!家人们放心用!

同时它还拿到了国家知识产权局的发明砖利证书,砖利证明,去不去🦶气资质说了算!

很多家人们反馈说,就连混合型、各种难愈、反反复复的类型也能有好效果!

它不仅能喷脚,还能喷鞋、喷袜子,一喷就能快速qu臭味、止yang、止疼,舒服一整天!

*自有版权,未经授权,盗图必究
02
李时珍中🌿院联合研发安全配方
0ji素不产生依赖,大人孩子放心用
它结合李时珍本草纲目中的精粹结合现代中🌿的lin床经验

*自有版权,未经授权,盗图必究
以苦参、侧柏为主辅以野菊花、白鲜皮、侧柏叶、土茯苓4大草本植物,历经500多次的实验的配方

其中研发团队从白鲜皮,侧柏叶中提取出”休复因子“,对外沙菌+对内休复+从内而外赶跑脚臭

它里面满满植物香气更能加强稳固🦶臭问题,不含ji素不会产生依赖性,连老人、孩子都能放心用

*自有版权,未经授权,盗图必究
长期坚持使用,不仅各种🦶臭问题变好,连🦶皮肤上的各种问题,肉眼可见的也好起来

*以实际使用效果为主,效果因人而异
很多人🦶气,很容易脚痒,这种状态是因为受到热刺激所致

这款足适爽中的土茯苓、侧柏叶植物精华,它们可能清燥热,止yang、jie热

喷上脚后凉凉的,彷佛泡在泉水里一样舒服,没一会儿就不痒了

结合现代工艺的透过皮肤技术,更能全访位将满满的中💊精华透进入肌肤深处

脚部皮肤自身的恢复能力也很强,只要你给它一个健康的足部环境,脱皮、干裂等就会渐渐消失,脚部很快就能长出健康细腻的新皮

*以实际使用效果为主,效果因人而异
03
喷剂设计,方便携带
没有🦶气坚持经常喷它也能预防传ran
小编中意它的喷剂设计,使用的时候不用接触脚部,不会沾染了脚臭味。

*自有版权,未经授权,盗图必究
喷雾非常细腻,可以深入到每一个脚趾缝,西菌镇菌藏到再隐蔽也不用害怕!

*以实际使用效果为主,效果因人而异
对比药膏,它还可以喷袜子、喷鞋子、全方面隔绝西菌危害,减少复发概率,非常方便~
实用实拍图


喷一次,舒服一整天,🦶气越重越出效果。

*自有版权,未经授权,盗图必究
一瓶100ml,比市面同类足足大了一倍。每天早晚各1次,10年老🦶气也足够用上3个月。

医学博士菲尔曼用它对256位🦶气人群做了临床实验,结果显示:
每天喷一次的人,比没有喷脚的人,脚臭、瘙痒、脱皮、干裂、溃烂发生率明显降低,脚部皮肤细腻度也明显提升!

所以说,🦶气能不能成功上岸全靠它了!有🦶气问题放心入吧!

【李时珍柏参足适爽保健喷剂】
华夏草本植物安全配方,专li认证
河南中🌿大学与李时珍研究院联合研发
官方价159/瓶,粉丝福利价39.9/瓶
买2送1,79.8到手3瓶,单瓶低至26.6
买3送2,119.7到手5瓶,单瓶低至23.94
给自己、长辈孩子,一人健康,全家安心
点击图片,立即购买▼
🦶有问题的家人们放心入吧!!!

*以上内容为广告推广
部分图片来源网络
如有侵权,请联系删除